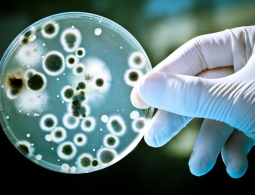
Восприимчивость бактерий к антибиотикам будут проверять с помощью смартфона

Российские ученые установили новый мировой рекорд сжатия вещества
МОСКВА, 20 дек — РИА Новости. Сотрудники Российского федерального ядерного центра (РФЯЦ-ВНИИЭФ, Саров, Нижегородская область) совместно со специалистами Российской академии наук установили новый мировой рекорд степени сжатия вещества. В ходе эксперимента было достигнуто давление...
Что будет с религией, если мы найдем инопланетян?
Поиск жизни на других планетах как-то совершенно не сходится, на первый взгляд, с верой в высшую силу, в Бога. И все же многие теологи уже открыли сердца для возможно существующих инопланетян, утверждает писатель Брэндон Амброзино. В 2014 году NASA передало 1,1 миллиона долларов Центру теологических...
Ученые справились с нарушением моторных навыков у мышей, страдающих болезнью Паркинсона
Болезнь Паркинсона является крайне неприятной, хорошо изученной и при этом неизлечимой болезнью. И недавно научной группе Хельсинкского университета под руководством доктора Тимо Мьоханена удалось совершить открытие, благодаря которому хоть и не удалось полностью справиться с заболеванием, но зато у...
Физики доказали, что антиматерия является зеркальной копией обычной материи
Ученые узнали на днях весьма интересную вещь об антиматерии. Согласно всей имеющейся на данный момент информации, антиматерия выглядит как точная зеркальная копия самой обычной материи. Но что это вообще значит?Теоретическая физика нам говорит, что каждая частица обладает античастицей. Например,...
Астрономы нашли еще одну звезду с необъяснимыми изменениями уровня светимости
Международная группа астрономов отмечает необычные изменения в светимости молодой звезды RIK-210, расположенной примерно в 472 световых годах от Земли. Со стороны все выглядит так, как будто свет этой звезды блокируется чем-то очень массивным. При этом ученые пока не могут понять, чем же именно....
Обнаружен источник таинственного сигнала, исходящего из Марианской впадины
Самая глубокая часть мирового океана на протяжении многих лет будоражит умы исследователей. Несколько лет назад со дна впадины начали доноситься странные звуки, которые были зафиксированы с поверхности океана. Звук обладает крайне странными характеристиками: это низкие тона в диапазоне от 38 до 8000...
Восприимчивость бактерий к антибиотикам будут проверять с помощью смартфона
Постоянная война человечества с устойчивыми к антибактериальной терапии штаммами микроорганизмов ведется давно, и не сказать чтобы в нашу пользу. Не малый вклад в развитие резистентных штаммов вкладывает и достаточно долгая процедура идентификации бактерий, которая длится от нескольких дней до неско...
Астероиды — не единственная угроза Земле из космоса
Мы думаем, что глубокий космос далекий и недостижимый, но на самом деле события в этом самом космосе могли помочь разогнаться эволюции жизни на Земле. Мы оказались здесь случайно. Эволюция могла пойти по другой ветке развития; любые шансы спонтанного появления жизни столь малы, что их можно назвать...
Ученые впервые омолодили целое животное стволовыми клетками
Ученые впервые применили метод клеточного репрограммирования для обращения вспять процесса клеточного старения живого организма. В качестве подопытных использовались специальные лабораторные мыши, у которых наблюдалась форма преждевременного старения. Метод клеточного репрограммирования показал 30-п...
Ученые выяснили, как новые "спайсы" превратили жителей Нью-Йорка в зомби
МОСКВА, 18 ноя – РИА Новости. Летом этого года несколько десятков жителей Нью-Йорка отравились новым видом "спайсов", созданным компанией Pfizer, чей сильнейший тормозящий эффект превращает людей в настоящих зомби с заторможенной реакцией, выяснили ученые, опубликовавш...
10 болезней, которые могли пожаловать к нам… из космоса
За многие годы многие ученые для себя убедились, что семена жизни вполне могли быть занесены на Землю метеоритами. Это теория панспермии, и она могла бы на многое ответить касательно нашего происхождения. К сожалению, как считают все те же ученые, инопланетные бактерии и вирусы по-прежнему могут про...
Как звучала бы речь обезьян, если бы они могли говорить
Человеческая речь помогает нам общаться и передавать друг другу информацию. Животные же для этого используют запахи, язык жестов и прочие способы. Долгое время считалось, что лишь люди способны общаться при помощи голоса, и даже наши ближайшие сородичи, приматы, несмотря на неоднократные попытки люд...